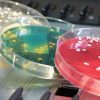

RECHERCHE DE DERMATOPHYTES : ONGLES, CHEVEUX, SQUAMES
Préconisations pour le prélèvement :
A effectuer de préférence au laboratoire.
– Ongles :
- Couper à l’aide de la pince à ongle ou des ciseaux toute la partie morte de l’ongle atteint,
- Gratter à la limite de la zone saine avec un vaccinostyle ou d’une curette,
- Recueillir et déposer les squames dans une boite de Pétri.
- En cas de lésion suintante, écouvillonner le pus et gratter le plancher de la lésion.
– Peaux :
- Identifier la zone lésée,
- A l’aide de la curette, prélever les squames en périphérie de la lésion, les déposer dans une boite de Pétri,
- L’application directe d’une lame adhésive sur les lésions est possible.
– Cheveux, poils :
- Identifier la zone lésée (teigne),
- Prélever les poils et cheveux à l’aide de la pince à épiler (racines nécessaires), à la limite de la peau saine et de la peau malade,
- Déposer l’ensemble dans une boite de Pétri.
Identifier les écouvillons avec les nom et prénom,
Noter la date du prélèvement.
Conservation et transport :
Le prélèvement doit être acheminé au laboratoire à température ambiante.
Renseignements : Renseignements administratifs, date de prélèvement, aspect des lésions, traitement anti infectieux le cas échéant